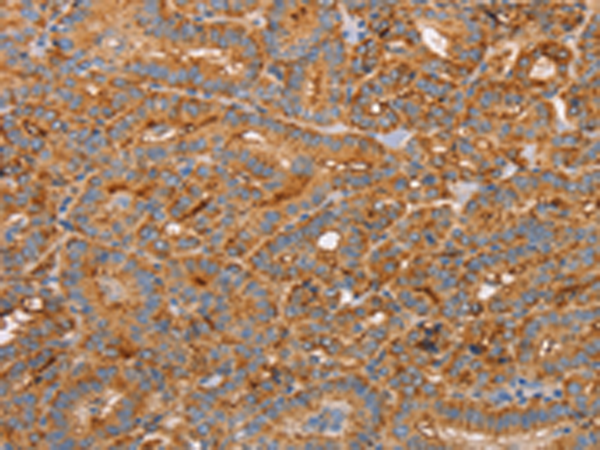

-
分类: 科研抗体货号: P04759别名: 1F5; EJ16; EJ30; EL32; G344; MIN1; MIN2; MIN3; MIRL; HRF20; MACIF; MEM43; MIC11; MSK21; 16.3A5; HRF-20; MAC-IP; p18-20应用: WB,IHC反应种属: Human
-
分类: 科研抗体货号: P04800别名: CRLR; CGRPR应用: WB,IHC反应种属: Human
-
分类: 科研抗体货号: P04685别名: APE; GIV; GRDN; HkRP1; GIRDIN; KIAA1212应用: IHC反应种属: Human, Mouse
-
分类: 科研抗体货号: P04758别名: NK1; CD57; HNK1; LEU7; NK-1; GLCATP; GLCUATP应用: WB,IHC反应种属: Human, Mouse, Rat
-
分类: 科研抗体货号: P04794别名: CRF1; CRHR; CRF-R; CRFR1; CRF-R1; CRFR-1; CRH-R1; CRHR1L; CRHR1f; CRF-R-1; CRH-R-1; CRH-R1h应用: IHC反应种属: Human
-
分类: 科研抗体货号: P04684别名: ANKYRIN-G应用: IHC反应种属: Human
-
分类: 科研抗体货号: P04752别名: FAT; GP4; GP3B; GPIV; CHDS7; PASIV; SCARB3; BDPLT10应用: WB,IHC反应种属: Human
-
分类: 科研抗体货号: P04793别名: AVSD2; CIRRIN应用: WB,IHC反应种属: Human, Mouse, Rat
-
分类: 科研抗体货号: P04681别名: LOG15; 12-LOX; 15-LOX; 15-LOX-1应用: WB,IHC反应种属: Human, Mouse, Rat
-
分类: 科研抗体货号: P04750别名: LY95; CD336; NKP44; NK-p44; dJ149M18.1应用: IHC反应种属: Human

鄂公网安备42018502007531号
鄂公网安备42018502007531号

